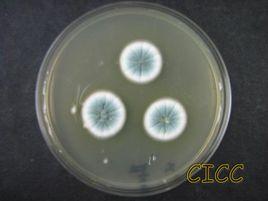
純綠青黴

純綠青黴基本信息
中文名稱:純綠青黴
拉丁名稱: Penicillium viridicatum
形態學:在CYA(察氏酵母提取物瓊脂)培養基上,25℃培養7d,生長局限,菌落質地絲絨狀,直徑19mm,孔雀石綠色,表面具放射狀皺紋,產淺黃色滲出液,有淺黃色可溶性色素產生,反面黃褐色。帚狀枝三輪生,有些二輪生,副枝1-2個;梗基12-15×3-4μm,每輪3-4個;梗頸較短,8-12×2-3μm;瓶梗10-15×2-3μm;分生孢子球形或近球形,直徑2.5-3.5μm,壁光滑 。
鑑定:GB/T 4789.16-2016 食品衛生微生物學檢驗 常見產毒黴菌的形態學鑑定中“純綠青黴的鑑定”。
鮮綠青黴(P.viridicatum)原名純綠青黴(P.viridicatum)
菌落在查氏瓊脂上25℃培養12d,直徑27mm~35mm;有少量放射狀皺紋或幾道同心環紋,偶有近於平坦者;質地絨狀兼顆粒狀;分生孢子結構在菌落邊緣或近邊緣大量產生,分生孢子面黃綠色,近於林肯綠色、阿月渾子綠色、孔雀石綠色;菌絲體白色中部面往往呈現微黃白色或淡褐色;滲出液淡黃淺褐色或缺乏;反面黃色或黃紅褐色;可溶性色素類似較淡的反面顏色或缺乏。
純綠青黴的分生孢子分生孢子梗發生於基質,孢梗莖150~300(~450)μm×35~4.5μm,壁顯著的疣狀粗糙;帚狀枝三輪生,偶有雙輪生或四輪生,彼此緊貼或較緊貼;副枝1~2個,14~25(~35)μm×3.2~4.0μm,壁顯著疣狀粗糙;梗基每輪2~5個,8.0~14(~16)μm×3.0~3.5μm,壁通常疣狀粗糙,頂端通常膨大;瓶梗每輪5~8個,7.0~11μm×2.2~2.8μm,瓶狀,梗頸短;分生孢子呈現球形或近球形,3.2~4.0(~4.5)μm,壁平滑,分生孢子鏈不規則或近於圓柱狀。
鮮綠青黴的某些菌株可產生褚麴黴毒素和桔青黴素 。
純綠青黴菌的代謝產物
發現純綠青毒菌(P.viridicatum)產生一些代謝產物,包括棕麴黴毒素A、桔黴素、未鑑定的一些毒素以及純綠青黴素(Viridicatin)、純綠青黴醇(Viridicatol)、純綠青黴酸(Viridicaticacid)、圓弧菌素(Cyclopenin)、圓弧菌醇(Cyclopenol)、霉酚酸(Mycophenolicacid)和brevianamideA。Carlfon等(1968-1970)的毒性試驗已證明,從美國印第安那州的小穀物和玉米得到的分離物對小鼠、大鼠、豚鼠和豬有毒性。化學鑑定結果和在幾種動物中引起的損害表明,上述純綠青黴菌的代謝產物與印第安那((Indiana)純綠青黴菌菌株的毒性無關,而鑑定出一些有色的代謝物,如黃麥格黴素(Xanthomegnin)、紫黃素(Viomelleiu)、紅硫黴素(Rubrosulphin)和紫紅紫素(Viopurpurin)等。
黃麥格黴素和紫黃素引起的小鼠肝臟損害
從純綠青黴產毒菌株的稻米培養物中分離出代謝產物,分別加入未污染的食物內,黃麥格黴素的濃度為448mg/kg飼料,而紫黃素的濃度為456mg/kg飼料。兩種飼料餵養兩組動物(每組六隻剛斷奶的雄性瑞士小鼠),餵養10天,自由進食和水,期滿後對所有小鼠進行屍體剖檢和病理組織學檢查。
在10天餵養期中,有3隻餵養黃麥格黴素食物的小鼠和兩隻餵養紫黃素的小鼠死亡,存活的小鼠體重增加減慢。兩個試驗組有同樣的損害,包括黃疸(6/12小鼠),腎臟變綠色(4/12),肝臟見有針尖樣淺棕褐至淡黃或淡綠色病灶(7/12),餵養這兩種代謝物的小鼠,其肝臟病理組織學改變相同,除一個肝臟之外,其他肝臟的病理解剖的改變都集中在肝內膽管周圍,包括壞死性膽管炎、膽管周圍水腫和膽管周圍炎,分散的灶性肝壞死為凝結型或液化型,膽管周圍纖維變性和膽管上皮的肥大和增生,肝外膽管和膽囊也發生壞死和炎性損害。腎臟的變化為腎小管腔中有少量至中等量的色素管型等。
餵養純綠青黴菌的這兩種代謝物黃麥格黴素和紫黃素的小鼠所觀察到的肝損害和以往報導餵養純綠青黴培養物粗製品的小鼠相同。看來可能這些代謝物單獨或以不同的組成與其它化學結構相似的物質一起可引起黴菌毒素中毒。
赫色青黴系培養物和棕麴黴群某些菌株的分離物所引起的小鼠肝臟損害和餵養純綠青黴培養物的小鼠相同,看來可能這些產毒黴菌也可產生這些或類似的代謝物 。